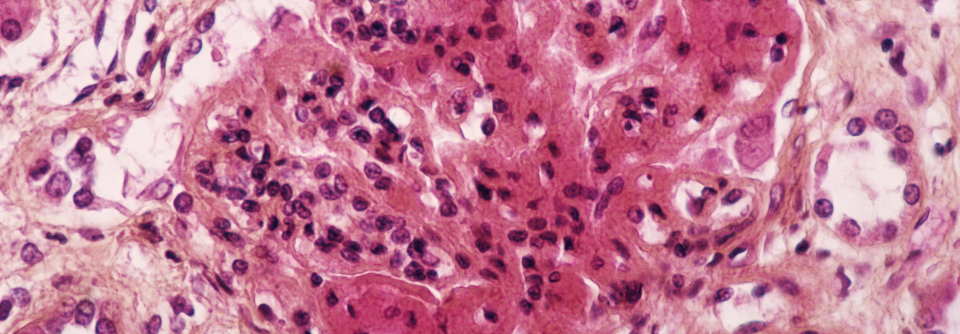

Systemischen Lupus erythematodes mit Hydroxychloroquin effektiv und sicher bändigen
 Eine gefürchtete kardiale Nebenwirkung unter HCQ ist das Long-QT-Syndrom.
© iStock/Junior Moreira
Eine gefürchtete kardiale Nebenwirkung unter HCQ ist das Long-QT-Syndrom.
© iStock/Junior Moreira
Die Anwendung von Hydroxychloroquin (HCQ) beim systemischen Lupus erythematodes (SLE) wird auch durch neue Daten gestützt, erklärte Professor Dr. Christoph Specker von der Klinik für Rheumatologie und Klinische Immunologie am Evangelischen Krankenhaus Essen-Werden. Die protektive Wirkung des Antimalariamittels bestätigte sich u.a. in einer Kohortenstudie mit 244 SLE-Patientinnen, die über mindestens zehn Jahre beobachtet wurden. Es galt: Je höher die durchschnittliche jährliche HCQ-Dosis, umso geringer der chronische Krankheitsschaden.
Trotzdem wird man häufig gefragt, ob man HCQ nicht wieder absetzen kann, wenn die Krankheit zur Ruhe gekommen ist, berichtete der Kollege. Auch hierzu…
Bitte geben Sie Ihren Benutzernamen und Ihr Passwort ein, um sich an der Website anzumelden.